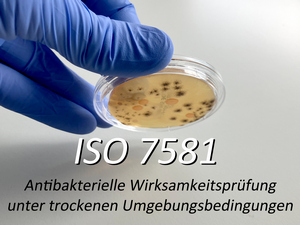
MTC ISO 7581

Ihr Kompetenzlabor für mikrobiologische Materialprüfungen.
Unser Antrieb: Die Welt jeden Tag ein bisschen sicherer machen!
Geprüfte Produkte schützen unsere Gesundheit und beugen Infektionen vor
Unser Labor MTC besitzt eine langjährige Expertise und Kompetenz in den Bereichen Molekularbiologie, Genetik, Immunologie, Mikrobiologie, Medizintechnik, mikrobiologischer Analysen, Prüfmethoden sowie der Entwicklung individueller Versuchssetups für neue Fragestellungen.
Der Fokus unseres Labors liegt auf der unabhängigen Beratung, Entwicklung und Durchführung mikrobiologischer Tests von Materialen und Produkten aller Art für die Einsatzbereiche Medizin, Pharmazie, Sanitär, Kosmetik, Farben, Lacke, Kunststoffe, Technik, Konsumartikel sowie die mikrobiologische Betreuung von Infektionsstudien.
Mikrobiologische Fragestellungen führen zunehmend durch wachsende Komplexität und Interdisziplinarität zu neuen Herausforderungen. Dabei werden vermehrt neben den Standardmethoden zur Evaluierung mikrobieller und antimikrobieller Eigenschaften auch produkt- und applikationsspezifische Methoden zum Nachweis einer nachhaltigen Wirksamkeit gefordert.
Daher erarbeiten wir auf wissenschaftlicher Basis, langjähriger Laborerfahrung und etablierter Prüfverfahren individuelle Lösungsansätze für Ihre mikrobiologischen Fragestellungen.
Neues aus unserem Labor
Haut-Mikrobiomtests für Tiere
Unser Labor hat das Spektrum unserer Mikrobiomtests auf die Mikrobiome von Hund, Katze, Pferd, Kuh und Kaninchen erweitert.
Darüber hinaus bieten wir verschiedene Prüfmethoden zum Nachweis der Wirksamkeit von Produkten gegenüber den Erregern von Hautinfektionen bei Tieren an.
„Die Höhle der Löwen“
Besuch von Dr. Jörg Brünke bei DS Produkte GmbH von Investor Ralf Dümmel mit Filmaufnahmen zur bekannten TV-Show „Die Höhle der Löwen“ mit Ausstrahlung am 9. September 2024 auf Vox.
ISO 7581 Testmethode
Neue Testmethode zur Untersuchung der antibakteriellen Wirksamkeit an Oberflächen unter trockenen Bedingungen.
„Die Höhle der Löwen“
Besuch von Investor Ralf Dümmel in unserem Labor für Filmaufnahmen zur bekannten TV-Show „Die Höhle der Löwen“ mit Ausstrahlung am 8. April 2024 auf Vox.
ISO 24072 Testmethode:
Prüfverfahren für die Aerosol-Bakterienrückhaltung beim Lufteinlass an Verabreichungsgeräten
Hautmikrobiom-Verträglichkeitstest:
Prüfverfahren zur Untersuchung der Verträglichkeit von Körperpflegeprodukten mit Mikroorganismen des Hautmikrobioms
+++ NEU – erweiterter Hautschutztest – NEU +++
Das Verfahren zur Überprüfung der Aufrechterhaltung des Hautschutz in Gegenwart von Kosmetika wurde erweitert und umfasst jetzt nicht nur ein bereits etabliertes Hautmikrobiomsystem, sondern auch ein System, welches sich in Gegenwart des Prüfproduktes erst entwickelt.
Veganer Hautmikrobiomtest:
Weltweit einzigartiges, speziell entwickeltes Tierprodukt-freies Testverfahren für die Testung veganer Kosmetikprodukte auf Hautmikrobiom-Verträglichkeit
Wir stellen uns gerne Ihren Herausforderungen! Kontaktieren Sie uns!

Wir setzen auf zufriedene Kunden durch geprüfte Qualität –
Unser Unternehmen ist durch den TÜV Rheinland zertifiziert.